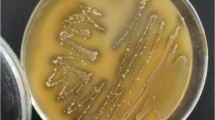

Abstract
Early microbial colonization is a determinant factor in animal health, and probiotic administration has been demonstrated to modulate intestinal microbiota and promote health in dairy calves. The objective of this study was to evaluate changes in calves’ fecal microbiota after the administration of two probiotic lactobacilli strains that had previously exhibited beneficial effects in calves’ health in relation to neonatal calf diarrhea. An in vivo assay was performed with 30 newborn male Holstein calves that were divided into three groups. Two groups were orally administered with two different lactobacilli strains (Lactobacillus johnsonii TP1.6 or Limosilactobacillus reuteri TP1.3B), and the third was the control group. Calves (5 to 9 days old) were administered with freeze-dried bacteria once a day for 10 consecutive days. Feces samples were taken before the first administration (day 0) and then again on days 10 and 21, and the V4 region of the bacterial 16S ribosomal gene was sequenced with an Illumina MiSeq 250 paired-end platform. The administration of both strains significantly affected the total bacterial community composition, and the effect lasted for 11 days after the last dose. In particular, amplicon sequence variants related to Bifidobacterium and Akkermansia genera were significantly higher in both treated groups. Therefore, modulation of the intestinal microbiota is a potential mechanism of action behind the beneficial effects of these probiotic strains.
Similar content being viewed by others
Avoid common mistakes on your manuscript.
Introduction
One of the most critical challenges in the dairy industry is the high mortality rate of calves, which affects the replacement of heifers. Despite preventive measures, enteric infections and neonatal calf diarrhea (NCD) are among the leading causes of newborn deaths [1, 2]. It is estimated that 5–6% of female dairy calves die during the preweaning period in farms in Canada and the USA [2]. In Uruguay, the annual calf mortality risk was estimated to be 15.2%, and diarrhea was reported as the most common clinical syndrome (85.2%) [3, 4]. Therefore, new strategies for improving the intestinal health of calves before weaning are necessary for minimizing their susceptibility to enteric infections and diarrhea. Mammals are born functionally sterile, and the colonization of the intestinal microbiota plays a fundamental role in the development of a competent and stable immune system [5]. The preservation of a normal microbial composition is necessary for both systemic and mucosal homeostasis [6, 7]; therefore, promoting a healthy intestinal microbiome is a topic of interest for animal production [8]. It has been suggested that the composition of the intestinal microbiota in the first stages of calves’ lives could be associated with susceptibility to enteric infections, indicating that individual variations in the intestinal microbiota may play an essential role in the pathogenesis of neonatal diarrhea [9,10,11,12]. For this reason, the number of studies exploring intestinal microbial composition, the mucosal immune system, and early manipulation of diet to improve the health of dairy calves has increased [8].
Consumer concerns and new regulations limit the prophylactic use of antimicrobials in animal production [13, 14], and therefore, the need for alternative approaches to improve animal health is urgent. Multidisciplinary strategies for improving intestinal health by manipulating the microbiome are surging [8], and one of them is the administration of probiotics to calves. In particular, lactobacilli strains have been widely described as probiotics and are considered crucial members of the gastrointestinal microbial community of animals [15, 16]. Studies have demonstrated that calves fed certain probiotic strains require less treatment against infectious diseases [17], and the incidence, severity, and duration of NCD can be reduced [18,19,20,21,22]. In one study, the use of probiotics had a better prophylactic effect on NCD compared with antibiotic-based treatments [23]. By contrast, many studies have reported no effect on health parameters [20, 24, 25]. It has been widely recognized that probiotic properties and mechanisms of action are strain-specific, which could — at least in part — explain the diverse results [26,27,28]. In addition, individualized host gut microbiota and immunity could indicate that the interaction between microbiota, host, and supplemented probiotics can be varied [28].
In a previous study, the strains Limosilactobacillus reuteri TP1.3B and Lactobacillus johnsonii TP1.6 were characterized as potential probiotics [29]. Both strains were originally isolated from healthy preweaned calves raised with their dams. Both were able to colonize the calves’ lower gastrointestinal tract (GIT), exhibited high resistance to acids and bile salts, adhered to mucus and Caco-2 cells, formed biofilms, and exerted antimicrobial effects against diarrhea-associated strains of Escherichia coli and Salmonella enterica sv. Typhimurium [29]. Most importantly, when tested in the field, both strains reduced diarrhea and fecal scores, thus improving calves’ health [30]. Action mechanisms proposed for probiotic effects include the modulation of the gut microbiota [31]. Thus, the aim of the present study was to determine whether the oral administration of these strains induced changes in the fecal microbiota of calves that could be associated with their beneficial effect and also whether this effect was maintained after administration ceased. We hypothesized that early-life administration of these probiotic strains would cause an increase in the abundance of health-promoting bacterial groups compared with an untreated control.
Materials and Methods
Bacterial Strains and Oral Dose Preparation
To prepare the inoculum for oral administration, strains were cultured and freeze-dried as previously described [29]. Briefly, strains were cultured in culture broth for 18 h in microaerophilic conditions, centrifuged (15.000 xg for 15 min) and washed twice with phosphate-buffered saline solution (PBS). The broth composition was designed to not contain any animal derivatives. The composition of the medium was K2HPO4 (2 g/L; Merck, Germany), C6H11NO7 (2 g/L; Merck), C2H3NaO2 (5 g/L; Merck), MgSO4·7H2O (0.2 g/L; Merck), MnSO4·H2O (0.04 g/L; Merck), Tween 80 (1 g/L; Merck), glucose (20 g/L; Merck), Phytone™ Peptone (25 g/L; Thermo Fisher Scientific, MA, USA), and yeast extract (25 g/L; Oxoid, England). Then, bacteria were suspended in 20% sterile skim milk (Conaprole, Uruguay), frozen at − 80 °C for 2 h, and freeze-dried for 24 h. Plate counts were performed to determine the number of colony-forming units (CFU) per gram of the freeze-dried product, and bacterial viability over time was confirmed. Individual doses were prepared such that each contained 2 × 1010 CFU.
Animal Handling and Housing
Animal handling was conducted under the constant supervision of veterinarians and with the approval of the Ethics Committee on the Use of Animals of the Instituto de Investigaciones Biológicas Clemente Estable (CEUA-IIBCE, reference number 001/02/2016). The assay was conducted at the experimental dairy farm of the Instituto Nacional de Investigación Agropecuaria (INIA, Colonia, Uruguay) with 30 Holstein male calves born in that location in March 2017. Immediately after birth, the calves had their navels dipped in a 7% iodine solution. Each calf received two doses of colostrum replacer (Saskatoon Colostrum Company, Canada), which was reconstituted following the manufacturer’s instructions (470 g in 2 L of distilled water). The first dose was administered within the first 3 h of birth and the second dose before 12 h. After 24 h, the passive transfer of immunity was confirmed by measuring the total protein concentration in serum [32] using a PAL-3 Digital Pocket Refractometer (Atago, Japan). Until 5 days of age, calves were kept in a shed and were bottle-fed twice a day with 2 L of fresh whole milk from the farm’s milk cooling tank. Then, the animals were placed outdoors randomly in a pasture field in stakes with 2-m neck chains and kept individually with limited moving space and with enough distance between them to prevent contact. This is a common rearing practice in Argentina, Brazil, and Uruguay [3]. Milk was provided in individual buckets, and the same feeding schedule was maintained with the addition of water and calf starter (Erro Nutriternera, Uruguay; 18% of crude protein). Water (2 L) and calf starter (300 g) were provided twice a day, 2 h after milk consumption. Every week, the calves were moved and placed randomly in different areas free of feces. No antimicrobials were administered before or during the assay.
Experimental Design and Sampling
Thirty calves were randomly assigned into three groups of 10 animals (see Table 1 for population characteristics). One group of calves was used as a control, and the other two groups were administered freeze-dried L. reuteri TP1.3B or L. johnsonii TP1.6. Calves started the treatment at 5 to 9 days of life (7 ± 1.4), which consisted of one daily oral dose of 2 × 1010 CFU for 10 consecutive days with the morning feeding. The dose consisted of a lyophilized powder containing the specified quantity of CFU, which was reconstituted in each calf’s individual bucket with the milk. The control group received the sterile lyophilization matrix. Individual fecal samples were taken directly from the rectal ampulla after stimulation with new and clean gloves each time. The first sample was taken before the first dose (day 0 of treatment), and on days 10 and 21 (refer to Supplementary Fig. S1 for the graphical layout of the experimental design). Hereinafter, days reference treatment administration rather than the calves’ age. Samples were immediately put on ice until they were transferred to a nearby − 80 °C freezer within 10 min.
DNA Extraction, 16S Sequencing, and Raw Data Processing
Frozen feces samples were thawed at room temperature and total microbial DNA extraction was performed using a ZR Fecal DNA MiniPrep™ Kit (ZYMO Research, CA, USA) following the manufactures’ protocol. The bead-beating step was performed using a FastPrep-24™ (MP Biomedicals, CA, USA) at 6 m/s for 40 s, and the extracted DNA was stored at – 20 °C. Library preparation and sequencing of the V4 region of the 16S rDNA gene was performed at the Center for Sequencing and Genomic Analysis, University of Austin (UT GSAF, Texas, USA), with an Illumina MiSeq platform for generating paired readings 250 bases in length. The generated data were processed with the R package dada2 [33] following the pipeline presented in the GitHub repository (https://benjjnn.g.gubub.io/dada2) and by Callahan et al. [34]. In summary, reads were trimmed and filtered using default parameters with truncLen = c(240,210) and trimLeft = 10. Amplicon sequence variants (ASVs) were defined and, after removing the chimeras (removeBimeraDenovo, method = “consensus”), taxonomy was assigned using the Silva database (version 132). ASVs with fewer than 10 reads in total were eliminated. DECIPHER was used to perform multiple sequence alignments [35], and phangorn [36] was used to construct a phylogenetic tree with the parameters recommended by Callahan et al. [34].
Statistical Analysis
The R packages phyloseq [37] and ampvis2 were used to visualize and analyze the sequencing data. Counts were normalized by calculating relative abundances for each ASV in each sample. With the normalized counts, distance matrices were calculated using the methods of Jaccard (presence/absence), Bray–Curtis (abundance), UniFrac (phylogenetic relationship), and Weighted-UniFrac (abundance-weighted phylogenetic relationship), and a nonmetric multidimensional scaling (NMDS) ordination was performed. Alpha-diversity parameters were calculated using the estimate_richness function, implemented in phyloseq with functions of the vegan package [38]. The calculated alpha-diversity parameters of treated groups were compared with the control group using a Kruskal–Wallis test (p value set at 0.05). To assess the effect of treatment and day on the bacterial community, a multivariate analysis of variance with permutations (PERMANOVA) was performed with the adonis function (vegan package) using the Bray–Curtis distance matrix (matrix ~ Treatment*Day). Then, pairwise comparisons were performed between the control groups and each treated group (p value set at 0.05). The functions betadisper and permutest were used to prove homogeneity of variance (permutations = 1000). Differential abundances between control and treated groups were determined with the DESeq2 package (test = “Wald”, fitType = “local”). The threshold for p-adjusted values by false discovery rate (FDR) was set at 0.1 (default).
Results
General Bacterial Composition
The fecal microbiota of 30 calves at three different times was characterized by sequencing the V4 region of the bacterial 16S rDNA (NBCI accession number of raw data PRJNA637605). Two samples (out of 90) could not be sequenced due to poor DNA quality. After filtering by quality and size and eliminating singletons and chimeras, 83.3% of the initial reads were retained, leaving an average of 14,841 (± 3,429) reads per sample. ASVs that were in low proportion (fewer than 10 total reads) were eliminated and 1,539 different ASVs were defined. A total of 24.8% of the ASVs could not be classified at the genus level. The most abundant phyla were Firmicutes, Bacteroidetes, and Actinobacteria, which together represented 74–99% of the total bacterial microbiota. Bacterial composition changed significantly in every group over time. Firmicutes abundance increased over time while Proteobacteria and Actinobacteria decreased (Fig. 1). The most abundant genera across all samples were Lactobacillus, Bacteroides, Blautia, Faecalibacterium, Collinsela, Subdoligranulum, Bifidobacterium, and Escherichia/Shigella (Fig. 2).
Heatmap of the 20 most abundant bacterial genera. Values represent the mean relative abundance (in percentage) for each genus. Data are presented by treatment (reference on top) and sampling day (reference on bottom). The sampling day refers to the day of treatment. Control refers to the control group, TP1.3B to the group administered with strain L. reuteri 1.3B, and TP1.6 to the group administered with strain L. johnsonii TP1.6 When no genus name was available, the best assignment is presented followed by the name of the representative ASV
Effect of Treatments on Fecal Microbial Composition
Richness, Shannon, Simpson, and evenness indices were calculated and analyzed as community descriptors (Fig. 3). Group TP1.3B did not exhibit significant differences from the control group, whereas group TP1.6 exhibited lower values of alpha-diversity parameters at day 10 (p < 0.05).
Alpha diversity indices. Richness, Shannon, Simpson, and evenness indices at every sampling point (referring to day of treatment). Each treated group was compared with the control group using a Kruskal–Wallis test (Control, control group; TP1.3B, group administered with strain L. reuteri TP1.3B; TP1.6, group administered with strain L. johnsonii TP1.6). Significant differences are presented with their respective p value
PERMANOVA was used to test the effects of treatment and day on the variation of microbial composition. Both variables and the interaction were significant (p < 0.05, refer to Table 2). Then PERMANOVA pairwise analysis was performed as a post hoc test. Group TP1.3B exhibited significant differences from the control group on day 21, whereas group TP1.6 exhibited differences from the control group on days 10 and 21 (p < 0.05). A summary of the statistically significant differences of pairwise comparisons with PERMANOVA is presented in Fig. 4, and a table containing all pairwise comparisons, F.model, R2, p values, and p values of permutest (homogeneity) is presented in the supplementary material (Table S1). No differences were found between the groups on day 0 (before the first dose) and intra-group dispersions were nonsignificant (Table S1). NMDS graphs were constructed using different distance calculation methods (Fig. 5); the day of sampling was observed to be an important variable shaping bacterial communities.
Pairwise PERMANOVA analysis. Scheme summarizing the pairwise comparisons that exhibited significant differences with the PERMANOVA analysis in the Bray–Curtis dissimilarity matrix between each treated group with the control (Control, control group; TP1.3B, group administered with strain L. reuteri TP1.3B; TP1.6, group administered with strain L. johnsonii TP1.6). Days 0, 10, and 21 refer to days of treatment. All pairwise comparisons with their corresponding F value, R2, p value, and p value of test of homogeneity are presented in detail in Table S1 in the supplementary material
Nonmetric multidimensional scaling (NMDS) ordination of different dissimilarity distance matrices. Different colors represent the three different treatments and different shapes represent the sampling days (referring to day of treatment). Control, control group; TP1.3B, group administered with strain L. reuteri TP1.3B; TP1.6, group administered with strain L. johnsonii TP1.6
Differential Abundances of ASVs Induced by Probiotic Administration
Differential abundance of ASVs was inferred with DESeq2 to determine specific changes in the bacterial community associated with probiotics administration (Figs. 6 and 7). Several changes in microbial composition were observed between the treated and control groups on days 10 and 21 (adjusted p values < 0.10), which meant that induced changes were not only observed during treatment but were maintained up to 11 days after the last probiotic dose (day 21). Differentially abundant ASVs accounted for 1–22% of the total abundance within each community. Several ASVs related to recognized beneficial genera were more abundant in both treated groups, such as Bifidobacterium and Akkermansia. The abundance of lactobacilli-related ASVs varied across groups without a clear pattern. ASVs named Seq1 and Seq2 had 100% homology with the 16S sequence of strains TP1.6 and TP1.3B, respectively. The relative abundances of both ASVs were analyzed, but no differences were found between the treated groups and control group (Fig. S2). Moreover, no differences were found in the relative abundance of ASVs related to the genus Escherichia/Shigella, a potential pathogen related to neonatal diarrhea, and no ASVs related to Salmonella or Campylobacter were detected.
Differential abundances of ASVs between the TP1.3B and control groups. A negative value of log2 FoldChange meant significantly more abundance in the control group for that ASV. ASV names are presented with the assigned genus. When no genus name was available, the best assignment is presented followed by “NA” and the name of the ASV. Days 10 and 21 refer to the day of treatment. Control, control group; TP1.3B, group administered with strain L. reuteri TP1.3B
Differential abundances of ASVs between the TP1.6 and control groups. A negative value of log2 FoldChange meant significantly more abundance in the control group for that ASV. ASV names are presented with the assigned genus. When no genus name was available, the best assignment is presented followed by “NA” and the name of the ASV. Days 10 and 21 refer to the day of treatment. Control, control group; TP1.6, group administered with strain L. johnsonii TP1.6
Discussion
In neonatal calves, the colonization of commensal bacteria in the GIT is crucial for the development of a competent and stable immune system [5]. Animals are born with a naive immune system and face environmental factors and pathogens during the first days of life. This is a crucial moment for the proper development of the microbiota and subsequently for the development of a functional immune system [39]. Probiotics could actively participate in this process through the competitive exclusion of undesirable microorganisms and the promotion of an homeostatic gastrointestinal environment [40]. Therefore, proposed mechanisms of action associated with probiotic administration include beneficial interactions with the host through the immune system and the modulation of the intestinal microbiota [31]. In a previous study, we demonstrated that the administration of strains TP1.3B and TP1.6 improved calves’ health by lowering fecal scores and diarrhea incidence [30]. In the present study, we aimed to determine whether the administration of the strains affected the composition of the intestinal microbiota of calves and whether the induced changes could represent a potential benefit to the host.
Most studies concerning intestinal microbiota in newborn ruminants have focused on the fecal microbiota because it is believed to be representative of the large intestine microbiota [41]. In our study, the general composition of the microbiota was similar to those in other previous studies that have described Firmicutes, Bacteroidetes, Proteobacteria, and Actinobacteria as the main phyla [9, 42, 43]. In this study, Firmicutes was the most abundant phylum and Lactobacillus spp. was the most abundant genus, which have been reported in other studies [44, 45]. The composition of the microbiota did not remain constant and significantly varied over time in every group of calves. This was expected because after birth, calves’ GIT continues to change anatomically and functionally until they are functioning ruminants [46]. For example, this study observed that the abundance of Firmicutes increased progressively, whereas the opposite occurred with Actinobacteria and Proteobacteria. The increase in Firmicutes over time in the GIT of calves is a phenomenon that has been previously described [44, 47, 48]. The most abundant genera also changed over time; for example, Ruminococcaceae_UCG-005 increased on day 21. This group, not yet cultured and characterized, has been described as the most abundant in the colon of weaned calves [45] and has been associated with the GIT of several species such as goats, camels, and deer [49,50,51].
In addition, the administration of strains TP1.3B and TP1.6 had significant effects on bacterial composition, which lasted for at least 11 days after the last dose. Differences in total bacterial composition between the control group and the group treated with strain TP1.6 could be observed after 10 days of strain administration (day 10) and after 11 days of the last dose (day 21). By contrast, differences between the control group and the TP1.3B group could be observed only on day 21. The fact that differences were found is promising since not many studies have reported significant changes in the intestinal microbiota of neonatal calves being caused by the administration of probiotics [45, 52] and up to 11 days after the cessation of treatment during a time of continuous anatomical and functional changes in the GIT. Moreover, differences were not observed before the administration (day 0); thus, differences were induced by the treatments and were not due to individual variation. In relation to alpha-diversity indices, no significant differences were found between the control group and the group treated with strain TP1.3B. However, group TP1.6 exhibited lower alpha-diversity indices compared with the control group. While decreased diversity is not desired, a debate exists about its role in the GIT, and the complexity of microorganism–host interactions makes it difficult to define the role of microbial diversity in health and disease [53].
The analysis with DESeq2 allowed us to assess which bacterial groups were significantly affected by the administration of the probiotic strains. Several ASVs that belonged to the genus Bifidobacterium were significantly more abundant in both probiotic treated groups. The presence of this genus in the gut has been associated with many health benefits for the host, such as the development of the infant gut and maintenance of the intestinal mucosal barrier and its immune response [54,55,56]. In calves, this genus has been characterized as part of the mucosa-associated microbial community of the intestine [47, 57, 58] and has been associated with the fecal microbiota of healthy non-diarrheic calves [59]. Consequently, Bifidobacterium spp. strains have been proposed as probiotics for calves with promising results [20]. Moreover, an increase in ASVs from the genus Akkermansia was observed in both treated groups. The species Akkermansia muciniphila resides in the intestinal mucus and regulates homeostasis and the integrity of the intestinal barrier through interaction with host signaling pathways [60]. Its abundance is inversely correlated with many diseases in humans, from metabolic to inflammatory, and is thus considered a “next generation” probiotic [61, 62]. In humans, its abundance is in the range of 1–5% [63], and it was found in a similar proportion in the present study. Derakhshani et al. determined that Akkermansia spp. was underrepresented in calves infected with Mycobacterium avium subspecies paratuberculosis [64]. This genus has not been studied as a probiotic in calves but isolating and characterizing strains for probiotic use could be of interest. Some of the observed differences between the treated and control groups were in taxa that have not been cultivated, mostly belonging to the Ruminococcaceae and Lachnospiraceae families; therefore, the interpretation of these changes and the determination of their role in the community are difficult. It is promising that changes in the bacterial community could be induced and observed during a period of constant anatomical changes for calves that significantly affect the microbiota, which could have potentially masked the effects of the probiotic treatments.
The limitations of this study include the feeding regime. Restricted diets are the most commonly used in Uruguay, with an average of 4.5 L of milk or milk replacer per day [3]. On the other hand, diets with a progressive increase in milk allow a greater daily weight gain, whereas a fixed volume forces the calf to start solid feeding early, promoting the development of the rumen [65,66,67]. Ad libitum milk feeding has been associated with poor performance and post-weaning growth retardation, probably due to delayed ruminal development [46]. In turn, some authors have observed that under diets with a higher milk supply or with a progressive increase, calves could suffer nutritional diarrhea (not associated with pathogens) and higher fecal score values [68,69,70]. However, other studies have reported no differences [71, 72]. The type of diet to use is highly debated and could affect the outcome of the results observed in this study. In future studies with these strains, other types of feeding regimes should be evaluated. Furthermore, more studies are required to determine whether the changes observed in the microbial community are maintained in the long term and how this could affect productivity.
The results of this study revealed that 10 days of administration with the strains L. johnsonii TP1.6 and L. reuteri TP1.3B significantly affected the intestinal microbial community of young calves; in particular, it increased the abundance of recognized beneficial taxa such as Bifidobacterium and Akkermansia. Modulation of the intestinal microbiota could be one mechanism of action of these strains for reducing calf diarrhea.
Data Availability
The sequencing data that support the findings of this study are available in the NCBI Sequence Read Archive under Accession Number PRJNA637605 (https://www.ncbi.nlm.nih.gov/bioproject/PRJNA637605, https://www.ncbi.nlm.nih.gov/bioproject/PRJNA637605).
References
Uetake K (2013) Newborn calf welfare: a review focusing on mortality rates. Anim Sci J 84:101–105. https://doi.org/10.1111/asj.12019
Urie NJ, Lombard JE, Shivley CB et al (2018) Preweaned heifer management on US dairy operations: part V. Factors associated with morbidity and mortality in preweaned dairy heifer calves. J Dairy Sci 101:9229–9244. https://doi.org/10.3168/JDS.2017-14019
Schild CO, Caffarena RD, Gil A et al (2020) A survey of management practices that influence calf welfare and an estimation of the annual calf mortality risk in pastured dairy herds in Uruguay. J Dairy Sci 103:9418–9429. https://doi.org/10.3168/jds.2020-18177
Caffarena RD, Casaux ML, Schild CO et al (2021) Causes of neonatal calf diarrhea and mortality in pasture-based dairy herds in Uruguay: a farm-matched case-control study. Braz J Microbiol 52:977–988. https://doi.org/10.1007/S42770-021-00440-3
Taschuk R, Griebel PPJ (2012) Commensal microbiome effects on mucosal immune system development in the ruminant gastrointestinal tract. Anim Health Res Rev 1:129–141. https://doi.org/10.1017/S1466252312000096
Bischoff SC (2011) “Gut health”: a new objective in medicine? BMC Med 9:24. https://doi.org/10.1186/1741-7015-9-24
Hooper LV, Littman DR, Macpherson AJ (2012) Interactions between the microbiota and the immune system. Science 336:1268–1273. https://doi.org/10.1126/science.1223490
Malmuthuge N, Guan LL (2017) Understanding the gut microbiome of dairy calves: opportunities to improve early-life gut health. J Dairy Sci 100:5996–6005. https://doi.org/10.3168/jds.2016-12239
Oikonomou G, Gustavo A, Teixeira V et al (2013) Fecal microbial diversity in pre-weaned dairy calves as described by pyrosequencing of metagenomic 16S rDNA. Associations of Faecalibacterium species with health and growth. PLoS One 8:e63157. https://doi.org/10.1371/journal.pone.0063157
Ma T, Villot C, Renaud D et al (2020) Linking perturbations to temporal changes in diversity, stability, and compositions of neonatal calf gut microbiota: prediction of diarrhea. ISME J 14:2223–2235. https://doi.org/10.1038/s41396-020-0678-3
Amin N, Seifert J (2021) Dynamic progression of the calf’s microbiome and its influence on host health. Comput Struct Biotechnol J 19:989–1001. https://doi.org/10.1016/j.csbj.2021.01.035
Malmuthuge N, Liang G, Griebel PJ, Guan LL (2019) Taxonomic and functional compositions of the small intestinal microbiome in neonatal calves provide a framework for understanding early life gut health. Appl Environ Microbiol 85:1–19. https://doi.org/10.1128/AEM.02534-18
Smith G (2015) Antimicrobial decision making for enteric diseases of cattle. Vet Clin North Am - Food Anim Pract 31:47–60. https://doi.org/10.1016/j.cvfa.2014.11.004
Lusk JL, Norwood FB, Pruitt JR (2006) Consumer demand for a ban on antibiotic drug use in pork production. Am J Agric Econ 88:1015–1033. https://doi.org/10.1111/J.1467-8276.2006.00913.X
Gaggìa F, Mattarelli P, Biavati B (2010) Probiotics and prebiotics in animal feeding for safe food production. Int J Food Microbiol 141:S15–S28. https://doi.org/10.1016/j.ijfoodmicro.2010.02.031
Uyeno Y, Shigemori S, Shimosato T (2015) Effect of probiotics/prebiotics on cattle health and productivity. Microbes Environ 30:126–132. https://doi.org/10.1264/jsme2.me14176
Musa HH, Wu SL, Zhu CH et al (2009) The potential benefits of probiotics in animal production and health. J Anim Vet Adv 8:313–321
Jatkauskas J, Vrotniakienė V (2014) Effects of encapsulated probiotic Enterococcus faecium strain on diarrhoea patterns and performance of early weaned calves. Vet Med (Praha) 67:494–503
Frizzo LS, Zbrun MV, Soto LP, Signorini ML (2011) Effects of probiotics on growth performance in young calves: a meta-analysis of randomized controlled trials. Anim Feed Sci Technol 169:147–156. https://doi.org/10.1016/j.anifeedsci.2011.06.009
Signorini ML, Soto LP, Zbrun MV et al (2012) Impact of probiotic administration on the health and fecal microbiota of young calves: a meta-analysis of randomized controlled trials of lactic acid bacteria. Res Vet Sci 93:250–258. https://doi.org/10.1016/j.rvsc.2011.05.001
von Buenau R, Jaekel L, Schubotz E et al (2005) Escherichia coli strain Nissle 1917: significant reduction of neonatal calf diarrhea. J Dairy Sci 88:317–323. https://doi.org/10.3168/jds.S0022-0302(05)72690-4
Renaud D, Kelton D, Weese J et al (2019) Evaluation of a multispecies probiotic as a supportive treatment for diarrhea in dairy calves: a randomized clinical trial. J Dairy Sci Sci 102:4498–4505. https://doi.org/10.3168/jds.2018-15793
Kim MK, Lee HG, Park JA et al (2011) Effect of feeding direct-fed microbial as an alternative to antibiotics for the prophylaxis of calf diarrhea in holstein calves. Asian-Australasian J Anim Sci 24:643–649. https://doi.org/10.5713/ajas.2011.10322
Cangiano LR, Yohe TT, Steele MA, Renaud DL (2020) Invited review: strategic use of microbial-based probiotics and prebiotics in dairy calf rearing. Appl Anim Sci 36:630–651. https://doi.org/10.15232/aas.2020-02049
He ZX, Ferlisi B, Eckert E et al (2017) Supplementing a yeast probiotic to pre-weaning Holstein calves: Feed intake, growth and fecal biomarkers of gut health. Anim Feed Sci Technol 226:81–87. https://doi.org/10.1016/j.anifeedsci.2017.02.010
Dunne C, Murphy L, Flynn S et al (1999) Probiotics: from myth to reality. Demonstration of functionality in animal models of disease and in human clinical trials. In: Konings WN, Kuipers OP, In ’t Veld JH (eds) Lactic acid bacteria: genetics, metabolism and applications. Springer, Dordrecht, pp 279–292
Chapman CMC, Gibson GR, Rowland I (2012) In vitro evaluation of single- and multi-strain probiotics: Inter-species inhibition between probiotic strains, and inhibition of pathogens. Anaerobe 18:405–413. https://doi.org/10.1016/j.anaerobe.2012.05.004
Ma T, Suzuki Y, Guan LL (2018) Dissect the mode of action of probiotics in affecting host-microbial interactions and immunity in food producing animals. Vet Immunol Immunopathol 205:35–48. https://doi.org/10.1016/j.vetimm.2018.10.004
Fernández S, Fraga M, Silveyra E et al (2018) Probiotic properties of native Lactobacillus spp. strains for dairy calves. Benef Microbes 9:613–624. https://doi.org/10.3920/BM2017.0131
Fernández S, Fraga M, Castells M et al (2020) Effect of the administration of Lactobacillus spp. strains on neonatal diarrhoea, immune parameters and pathogen abundance in pre-weaned calves. Benef Microbes 11:477–488. https://doi.org/10.3920/BM2019.0167
O’Toole PW, Cooney JC (2008) Probiotic bacteria influence the composition and function of the intestinal microbiota. Interdiscip Perspect Infect Dis 2008:175285. https://doi.org/10.1155/2008/175285
Morrill KM, Polo J, Lago A et al (2013) Estimate of serum immunoglobulin G concentration using refractometry with or without caprylic acid fractionation. J Dairy Sci 96:4535–4541. https://doi.org/10.3168/jds.2012-5843
Callahan B, McMurdie P, Rosen M et al (2016) DADA2: High-resolution sample inference from Illumina amplicon data. Nat Methods 13:581–583. https://doi.org/10.1038/nmeth.3869
Callahan B, Sankaran K, Fukuyama J et al (2016) Bioconductor workflow for microbiome data analysis: from raw reads to community analyses. F1000Research 5:1492. https://doi.org/10.12688/f1000research.8986.2
Wright ES (2015) DECIPHER: Harnessing local sequence context to improve protein multiple sequence alignment. BMC Bioinformatics 16:1–14. https://doi.org/10.1186/s12859-015-0749-z
Schliep KP (2011) phangorn: phylogenetic analysis in R. Bioinformatics 27:592–593. https://doi.org/10.1093/bioinformatics/btq706
McMurdie PJ, Holmes S (2013) Phyloseq: an R package for reproducible interactive analysis and graphics of microbiome census data. PLoS One 8:e61217. https://doi.org/10.1371/journal.pone.0061217
Oksanen J, Blanchet F, Friendly M et al (2019) vegan: community ecology package. R package version 2.5–4.
Wilson RA, Zolnai A, Rudas P, Frenyo LV (1996) T-cell subsets in blood and lymphoid tissues obtained from fetal calves, maturing calve, and adult bovine. Vet Immunol Immunopathol 53:49–60. https://doi.org/10.1016/0165-2427(95)05543-6
Borchers AT, Selmi C, Meyers FJ et al (2009) Probiotics and immunity. J Gastroenterol 44:26–46. https://doi.org/10.1007/s00535-008-2296-0
Meale SJ, Chaucheyras-Durand F, Berends H et al (2017) From pre- to postweaning: transformation of the young calf’s gastrointestinal tract. J Dairy Sci 100:5984–5995. https://doi.org/10.3168/jds.2016-12474
Meale SJ, Li S, Azevedo P et al (2016) Development of ruminal and fecal microbiomes are affected by weaning but not weaning strategy in dairy calves. Front Microbiol 7:1–16. https://doi.org/10.3389/fmicb.2016.00582
Alipour MJ, Jalanka J, Pessa-Morikawa T et al (2018) The composition of the perinatal intestinal microbiota in cattle. Sci Rep 8:1–14. https://doi.org/10.1038/s41598-018-28733-y
Castro JJ, Gomez A, White B et al (2016) Changes in the intestinal bacterial community, short-chain fatty acid profile, and intestinal development of preweaned Holstein calves. 2. Effects of gastrointestinal site and age. J Dairy Sci 99:9703–9715. https://doi.org/10.3168/jds.2016-11007
Fomenky BE, Do DN, Talbot G et al (2018) Direct-fed microbial supplementation influences the bacteria community composition of the gastrointestinal tract of pre- and post-weaned calves. Sci Rep 8:1–21. https://doi.org/10.1038/s41598-018-32375-5
Baldwin VIRL, McLeod KR, Klotz JL, Heitmann RN (2004) Rumen development, intestinal growth and hepatic metabolism in the pre- and postweaning ruminant. J Dairy Sci 87:E55–E65. https://doi.org/10.3168/jds.s0022-0302(04)70061-2
Malmuthuge N, Griebel PJ, Guan LL (2015) The gut microbiome and its potential role in the development and function of newborn calf gastrointestinal tract. Front Vet Sci 2:1–10. https://doi.org/10.3389/fvets.2015.00036
Wang SX, Zhang J, Li SL et al (2017) Influence of dairy by-product waste milk on the microbiomes of different gastrointestinal tract components in pre-weaned dairy calves. Sci Rep 7:1–13. https://doi.org/10.1038/srep42689
Guan Y, Yang H, Han S et al (2017) Comparison of the gut microbiota composition between wild and captive sika deer (Cervus nippon hortulorum) from feces by high-throughput sequencing. AMB Express 7:1–13. https://doi.org/10.1186/s13568-017-0517-8
Wang Y, Zhang H, LinZhu LZ et al (2018) Dynamic distribution of gut microbiota in goats at different ages and health states. Front Microbiol 9:2509. https://doi.org/10.3389/fmicb.2018.02509
He J, Hai L, Orgoldol K et al (2019) High-throughput sequencing reveals the gut microbiome of the bactrian camel in different ages. Curr Microbiol 76:810–817. https://doi.org/10.1007/s00284-019-01689-6
Du R, Jiao S, Dai Y et al (2018) Probiotic Bacillus amyloliquefaciens C-1 improves growth performance, stimulates GH/IGF-1, and regulates the gut microbiota of growth-retarded beef calves. Front Microbiol 9:1–12. https://doi.org/10.3389/fmicb.2018.02006
Gerritsen J, Smidt H, Rijkers GT, de Vos WM (2011) Intestinal microbiota in human health and disease: the impact of probiotics. Genes Nutr 6:209–240. https://doi.org/10.1007/s12263-011-0229-7
Leahy SC, Higgins DG, Fitzgerald GF, Van Sinderen D (2005) Getting better with bifidobacteria. J Appl Microbiol 98:1303–1315. https://doi.org/10.1111/j.1365-2672.2005.02600.x
Vlasova AN, Kandasamy S, Chattha KS et al (2016) Comparison of probiotic lactobacilli and bifidobacteria effects, immune responses and rotavirus vaccines and infection in different host species. Vet Immunol Immunopathol 172:72–84. https://doi.org/10.1016/j.vetimm.2016.01.003
Sarkar A, Mandal S (2016) Bifidobacteria—Insight into clinical outcomes and mechanisms of its probiotic action. Microbiol Res 192:159–171. https://doi.org/10.1016/j.micres.2016.07.001
Malmuthuge N, Chen Y, Liang G et al (2015) Heat-treated colostrum feeding promotes beneficial bacteria colonization in the small intestine of neonatal calves. J Dairy Sci 98:8044–8053. https://doi.org/10.3168/jds.2015-9607
Song Y, Malmuthuge N, Li F, Guan LL (2018) Colostrum feeding shapes the hindgut microbiota of dairy calves during the first 12 h of life. FEMS Microbiol Ecol 95:fiy203. https://doi.org/10.1093/femsec/fiy203
Gomez DE, Arroyo LG, Costa MC et al (2017) Characterization of the fecal bacterial microbiota of healthy and diarrheic dairy calves. J Vet Intern Med 31:928–939. https://doi.org/10.1111/jvim.14695
Shin J, Noh J-R, Chang D-H et al (2019) Elucidation of Akkermansia muciniphila probiotic traits driven by mucin depletion. Front Microbiol 10:1137. https://doi.org/10.3389/fmicb.2019.01137
Cani PD, de Vos WM (2017) Next-generation beneficial microbes: the case of Akkermansia muciniphila. Front Microbiol 8:1765. https://doi.org/10.3389/fmicb.2017.01765
Zhai Q, Feng S, Arjan N, Chen W (2018) A next generation probiotic, Akkermansia muciniphila. Crit Rev Food Sci Nutr 59:3227–3236. https://doi.org/10.1080/10408398.2018.1517725
Belzer C, De Vos WM (2012) Microbes inside-from diversity to function: the case of Akkermansia. ISME J 6:1449–1458. https://doi.org/10.1038/ismej.2012.6
Derakhshani H, De Buck J, Mortier R et al (2016) The features of fecal and ileal mucosa-associated microbiota in dairy calves during early infection with Mycobacterium avium subspecies paratuberculosis. Front Microbiol 7:426. https://doi.org/10.3389/FMICB.2016.00426
Drackley JK (2008) Calf nutrition from birth to breeding. Vet Clin North Am - Food Anim Pract 24:55–86. https://doi.org/10.1016/j.cvfa.2008.01.001
Khan MA, Weary DM, von Keyserlingk MAG (2011) Invited review: effects of milk ration on solid feed intake, weaning, and performance in dairy heifers. J Dairy Sci 94:1071–1081. https://doi.org/10.3168/jds.2010-3733
Kertz AF, Hill TM, Quigley JD et al (2017) A 100-year review: calf nutrition and management. J Dairy Sci 100:10151–10172. https://doi.org/10.3168/jds.2017-13062
Quigley JD, Wolfe TA, Elsasser TH (2010) Effects of additional milk replacer feeding on calf health, growth, and selected blood metabolites in calves. J Dairy Sci 89:207–216. https://doi.org/10.3168/jds.s0022-0302(06)72085-9
Daneshvar D, Khorvash M, Ghasemi E, Mahdavi AH (2017) Combination effects of milk feeding methods and starter crude protein concentration: evaluation on performance and health of Holstein male calves. Anim Feed Sci Technol 23:1–12. https://doi.org/10.1016/j.anifeedsci.2016.10.025
de Paula MR, Oltramari CE, Silva JT et al (2017) Intensive liquid feeding of dairy calves with a medium crude protein milk replacer: effects on performance, rumen, and blood parameters. J Dairy Sci 100:4448–4456. https://doi.org/10.3168/jds.2016-10859
Khan MA, Lee HJ, Lee WS et al (2007) Structural growth, rumen development, and metabolic and immune responses of Holstein male calves fed milk through step-down and conventional methods. J Dairy Sci 90:3376–3387. https://doi.org/10.3168/jds.2007-0104
Omidi-Mirzaei H, Khorvash M, Ghorbani GR et al (2015) Effects of the step-up/step-down and step-down milk feeding procedures on the performance, structural growth, and blood metabolites of Holstein dairy calves. J Dairy Sci 98:7975–7981. https://doi.org/10.3168/jds.2014-9260
Funding
This work was supported by the Instituto Nacional de Investigación Agropecuaria (INIA, Uruguay, grant number: FPTA 325) and by a student grant from Agencia Nacional de Investigación e Innovación (ANII, Uruguay, grant number: POS_NAC_2013_1_11186).
Author information
Authors and Affiliations
Contributions
Sofía Fernández-Ciganda: conceptualization, methodology, laboratory work, formal analysis, and writing of the original draft. Martín Fraga: academic and technical input and proofreading of the manuscript. Pablo Zunino: academic and technical input, supervision, and project administration.
Corresponding author
Ethics declarations
Ethics Approval
Animal handling was conducted at the Instituto Nacional de Investigación Agropecuaria under the constant supervision of veterinarians and with the approval of the Ethics Committee on the Use of Animals of the Instituto de Investigaciones Biológicas Clemente Estable (CEUA-IIBCE, reference number 001/02/2016, date: 5th of February of 2016).
Conflict of Interest
The authors declare no competing interest.
Additional information
Publisher's Note
Springer Nature remains neutral with regard to jurisdictional claims in published maps and institutional affiliations.
Supplementary Information
Below is the link to the electronic supplementary material.
Rights and permissions
About this article
Cite this article
Fernández-Ciganda, S., Fraga, M. & Zunino, P. Probiotic Lactobacilli Administration Induces Changes in the Fecal Microbiota of Preweaned Dairy Calves. Probiotics & Antimicro. Prot. 14, 804–815 (2022). https://doi.org/10.1007/s12602-021-09834-z
Accepted:
Published:
Issue Date:
DOI: https://doi.org/10.1007/s12602-021-09834-z